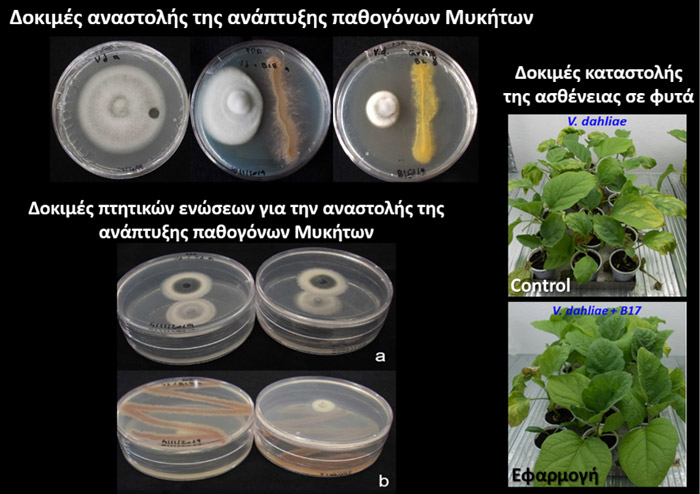

Ερευνητικό πρόγραμμα «BIOCONTROL – Βιώσιμες λύσεις για την βιολογική αντιμετώπιση επιβλαβών μικροοργανισμών και την επαγωγή της αντοχής των καλλιεργειών στην αλατότητα»

Τρεις από τους σημαντικότερους ερευνητικούς φορείς της χώρας, με έδρα την Κρήτη: α) το Ινστιτούτο Μοριακής Βιολογίας και Βιοτεχνολογίας, Ίδρυμα Τεχνολογίας και Έρευνας (ΙΜΒΒ-ΙΤΕ), β) το Τμήμα Γεωπονίας του Ελληνικού Μεσογειακού Πανεπιστημίου (ΤΓΕΠ-ΕΛΜΕΠΑ) και γ) το Ινστιτούτο Ελιάς, Υποτροπικών Φυτών και Αμπέλου, του Ελληνικού Γεωργικού Οργανισμού ΔΗΜΗΤΡΑ (ΙΕΛΥΑ – ΕΛΓΟ ΔΗΜΗΤΡΑ), συνεργάζονται με μία από τις μεγαλύτερες επιχειρήσεις στον χώρο της Αγροδιατροφής, της «Ραιδεστός» των Κ & Ν Ευθυμιάδης, για την ανάπτυξη καινοτόμων μεθόδων αντιμετώπισης επιβλαβών μικροοργανισμών των καλλιεργειών, καθώς και της επαγωγής της ανθεκτικότητας τους στην αυξημένη αλατότητα.
Η εντατικοποίηση της Γεωργίας, η παγκόσμια πληθυσμιακή αύξηση και η ραγδαία κλιματική αλλαγή έχουν οδηγήσει στην υποβάθμιση των αγροτικών εδαφών, την εμφάνιση πιο μολυσματικών στελεχών γνωστών παθογόνων και την ανάδυση νέων καταστροφικών παθογόνων (π.χ. Xylella fastidiosa στην ελιά, κ.ά.).
Τα προβλήματα αυτά αναμένεται να ενταθούν λόγω του επικείμενου περιορισμού στην χρήση πολλών φυτοπροστατευτικών δραστικών ενώσεων από την Ευρωπαϊκή Επιτροπή Περιβάλλοντος (οδηγία 2009/128/ΕΚ), με αποτέλεσμα να γίνεται επιτακτική και άμεση η ανάγκη εύρεσης νέων αειφόρων μεθόδων και προϊόντων βιολογικής αντιμετώπισης.
Λαμβάνοντας υπόψιν τα παραπάνω, στο παρόν έργο (BIOCONTROL), εξετάζονται δυο συμπληρωματικές στρατηγικές για την προστασία των καλλιεργειών:
- Η πρώτη αφορά την απομόνωση ωφέλιμων μικροβίων, από άγρια φυτικά είδη (συγγενικά των καλλιεργούμενων) που διαβιούν σε ακραία περιβάλλοντα, για την διερεύνηση της χρήσης τους ως «Βιο-εμβόλια». Σκοπός του εγχειρήματος αυτού είναι η ανάπτυξη νέων μεθοδολογικών προσεγγίσεων στην παραγωγική διαδικασία, για την αντιμετώπιση επιλεγμένων φυτοπαθογόνων μικροβίων αλλά και των δυσμενών επιδράσεων της αυξημένης αλατότητας των εδαφών.
Προκαταρκτικά πειράματα, ανέδειξαν τη δυνατότητα διαφόρων μικροβιακών στελεχών να προστατεύουν τα φυτά από τη βερτισιλλίωση (Verticillium dahliae), καθώς και από τα βακτήρια καραντίνας Ralstonia solanacearum και Clavibacter michiganensis subsp. michiganensis, καθιστώντας τα ταυτόχρονα ιδιαιτέρως ανεκτικά στην υψηλή αλατότητα. Τα απομονωμένα στελέχη θα εμπλουτίσουν την υπάρχουσα τράπεζα γενετικού υλικού και θα χρησιμοποιηθούν για τον μετέπειτα σχεδιασμό εμπορικών σκευασμάτων (συνθετικών μικροβιακών κοινοτήτων).
- Η δεύτερη προσέγγιση αφορά στην καινοτόμο παραγωγή επιλεγμένων φυτικών «Βιοενεργών ενώσεων» μέσα από καλά σχεδιασμένα βιολογικά εργοστάσια. Οι ουσίες αυτές που στη φύση παράγονται στην ελιά (υδροξυτυροσόλη) και στο αμπέλι (ρεσβερατρόλη) έχουν δείξει σημαντική δράση ενάντια σε σημαντικά παθογόνα των καλλιεργειών. Σκοπός του εγχειρήματος είναι η βελτιστοποίηση του συστήματος παραγωγής ώστε να μπορέσει να υποστηρίξει την παραγωγή σε μεγαλύτερη κλίμακα για την γενικευμένη χρήση τους στη γεωργία.
Τα σκευάσματα φυτικών Βιοενεργών ενώσεων, τα Βιο-εμβόλια ωφέλιμων μικροοργανισμών και τα πρωτόκολλα φυτοπροστασίας που θα αναπτυχθούν, θα δοκιμαστούν από την εταιρεία «Ραιδεστός», με σκοπό τον έλεγχο τους στο πεδίο και τον έλεγχο της απόδοσης τους με στόχο την αξιοποίηση τους ως εμπορικά προϊόντα/σκευάσματα.

Εκ μέρους των ερευνητικών ομάδων:
Δρ. Παναγιώτης Σαρρής, Συντονιστής, Καθ. Μικροβιολογίας Πανεπ. Κρήτης & ΙΜΒΒ-ΙΤΕ
Δρ. Εμμανουήλ Τραντάς, Εκπρόσωπος ΕΛΜΕΠΑ, Καθ. Γονιδιωματικής Ανάλυσης και Μεταβολικής Μηχανικής
Δρ. Εμμανουήλ Μαρκάκης, Εκπρόσωπος ΕΛΓΟ-ΔΗΜΗΤΡΑ, Ερευν. Μυκητολογίας
Ρεβέκκα Στεφανίδου, Εκπρόσωπος «Ραιδεστός» Κ & Ν Ευθυμιάδης, Γεωπόνος
 Το Έργο υλοποιείται στο πλαίσιο της Ενιαίας Δράσης Κρατικών Ενισχύσεων Έρευνας, Τεχνολογικής Ανάπτυξης & Καινοτομίας «ΕΡΕΥΝΩ – ΔΗΜΙΟΥΡΓΩ – ΚΑΙΝΟΤΟΜΩ» του Ε.Π. «Ανταγωνιστικότητα, Επιχειρηματικότητα και Καινοτομία» (ΕΠΑνΕΚ) 2014-2020 και συγχρηματοδοτείται από το Ευρωπαϊκό Ταμείο Περιφερειακής Ανάπτυξης (ΕΤΠΑ)
Το Έργο υλοποιείται στο πλαίσιο της Ενιαίας Δράσης Κρατικών Ενισχύσεων Έρευνας, Τεχνολογικής Ανάπτυξης & Καινοτομίας «ΕΡΕΥΝΩ – ΔΗΜΙΟΥΡΓΩ – ΚΑΙΝΟΤΟΜΩ» του Ε.Π. «Ανταγωνιστικότητα, Επιχειρηματικότητα και Καινοτομία» (ΕΠΑνΕΚ) 2014-2020 και συγχρηματοδοτείται από το Ευρωπαϊκό Ταμείο Περιφερειακής Ανάπτυξης (ΕΤΠΑ)







